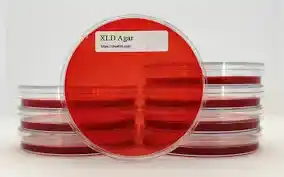

محیط کشت XLD آگار کدمرک 105287
محیط کشت XLD آگار (Xylose Lysine Deoxycholate Agar) یکی از محیطهای کشت انتخابی–افتراقی پرکاربرد در میکروبیولوژی است که بهطور ویژه برای جداسازی و شناسایی باکتریهای سالمونلا و شیگلا در نمونههای بالینی، غذایی و آب مورد استفاده قرار میگیرد.
این محیط کشت به دلیل ترکیب دقیق و واکنشهای بیوشیمیایی قابل اعتماد، جایگاه ویژهای در آزمایشگاههای تشخیص طبی، کنترل کیفیت مواد غذایی و مراکز تحقیقاتی دارد.
محیط کشت XLD آگار مرک آلمان با کد 105287 ارائهشده توسط دانش پژوهان شیمی، با گرید میکروبیولوژی و کیفیت تضمینشده عرضه میشود و انتخابی مطمئن برای آزمایشگاههای دانشگاهی، مراکز تشخیص طبی، صنایع غذایی و واحدهای QC است.
این محصول با عملکرد پایدار و نتایج تکرارپذیر، نیاز کاربران حرفهای را در فرآیندهای آنالیز میکروبی بهطور کامل پوشش میدهد.
در شرکت دانش پژوهان شیمی، اصالت و کیفیت کالا برای ما در اولویت است. شما میتوانید محیط کشت XLD آگار آزمایشگاهی معتبر Merck را همراه با برگه آنالیز (COA)، بستهبندی استاندارد و مشاوره علمی تخصصی دریافت کنید.
📌 این محصول با کد 105287 آماده عرضه میباشد.
برای ثبت سفارش و دریافت قیمت روز، با کارشناسان ما تماس بگیرید:
-
☎️ تلفن: 02166859220(ساعات پاسخگویی: 8:30 تا 18:00)
-
📱 واتساپ: 09129618292 (پشتیبانی 24 ساعته)
دانشجویان، پژوهشگران و فعالان حوزه تحقیقاتی میتوانند با اطمینان خاطر، این ماده شیمیایی را از دانش پژوهان شیمی تهیه کنند و پروژههای آزمایشگاهی خود را با کیفیت و دقت بیشتری پیش ببرند.
محیط کشت XLD آگار
محیط کشت XLD ابتدا توسط توماس برای تشخیص و ایزولاسیون باکتریهای ایشریشیا کلیها توسعه داده شد. این محیط کشت اصلاح شده در دهه 1930 به عنوان یک محیط انتخابی برای باکتریهای ایشریشیا کلی به کار گرفته شد و به سرعت تبدیل به محبوبترین محیط کشت برای این منظور شد.
شرکت دانش پژوهان شیمی واردکننده اصلی مواد شیمیایی آزمایشگاهی بخصوص برند مرک آلمان و سیگماآلدریچ در ایران می باشد. جهت خرید محیط کشت می توانید با همکاران این مجموعه تماس حاصل نمائید.
مشخصات فنی محیط کشت XLD آگار
-
نام محصول: XLD Agar (Xylose Lysine Deoxycholate Agar)
-
برند: Merck (آلمان)
-
کد محصول: 105287
-
گرید: میکروبیولوژی
-
فرم: پودر
-
کاربرد: محیط کشت انتخابی–افتراقی
-
مناسب برای: سالمونلا و شیگلا
-
بستهبندی: استاندارد آزمایشگاهی
-
قابلیت اتوکلاو: دارد
دعوت ویژه برای بازدید از محصولات و مقالات ما
از شما دعوت میکنیم برای آشنایی بیشتر با محصولات آزمایشگاهی و مقالات تخصصی ما، سری به وبسایت بزنید و سایر محصولات از جمله نیترات کلسیم کد 102121 را مشاهده کنید. هدف ما این است که فرآیند خرید شما سریعتر، آسانتر و با اطمینان کامل انجام شود.
همین حالا روی لینک زیر کلیک کنید و از محتوای آموزشی و محصولات متنوع ما دیدن کنید:
ترکیب محیط کشت XLD
ترکیب محیط کشت XLD شامل موارد زیر است:
- پپتون: پپتون به عنوان منبع اصلی نیتروژن و مواد مغذی برای رشد باکتریها در محیط کشت عمل میکند.
- گلوکز: گلوکز به عنوان منبع کربن و انرژی برای رشد باکتریها استفاده میشود.
- لیزین: لیزین به عنوان یک منبع اختصاصی از نیتروژن برای باکتریهای ایشریشیا کلی و ایشریشیا تیفی در این محیط کشت حضور دارد. محیط کشت XLD آگار کدمرک 105287
- دئوکسیکولات سدیم: این ماده به عنوان یک مهارکننده پتانسیل هیدروژن (pH) برای کنترل تجزیه یا ایزولاسیون باکتریهای چیپولا و اشریشیا کلی در محیط کشت استفاده میشود. محی ط کشت XLD آگار کدمرک : 105287
- لکتوز: لکتوز به عنوان یک منبع اضافی کربن و انرژی برای باکتریها عمل میکند. محیط کشت XLD آگار کدمرک 105287
- کلرید سدیم: این ماده به عنوان منبع یون سدیم در محیط کشت حضور دارد. محیط کشت XLD آگار کدمرک 105287
- سولفید فریروز (Ferric Sulfide): این ترکیب به عنوان یک مؤشر جهت تشخیص تشکیل گاز هیدروژن سولفید توسط باکتریها در محیط کشت عمل میکند. محیط کشت XLD آگار کدمرک 105287
3.اهداف محیط کشت XLD:
محیط کشت XLD طراحی شده است تا اهداف خاصی را برای تشخیص و ایزوله کردن باکتریهای ایشریشیا کلی و باکتریهای مرتبط با این گونه داشته باشد. این اهداف عبارتاند از: محیط کشت XLD آگار کدمرک 105287
تشخیص باکتریهای ایشریشیا کلی (Escherichia coli) و ایشریشیا تیفی (Escherichia typhi).
تشخیص تشکیل گاز هیدروژن سولفید توسط باکتریها. محیط کشت XLD آگار کدمرک 105287
جداسازی و شناسایی باکتریهای ایشریشیا کلی از دیگر باکتریها و قارچها. محیط کشت XLD آگار کدمرک 105287
4. اصول عملکرد محیط کشت XLD:
عملکرد محیط کشت XLD بر اساس تفاوتهای در رشد و ویژگیهای باکتریها در مقابل مواد موجود در ترکیب محیط کشت انجام میشود: مح یط کشت XLD آگار کدمرک : 105287
- رنگ آبی شفاف: باکتریهای غیر ایشریشیا کلی (غیر E. coli) که قادر به تبدیل لیزین به امونیاک نیستند، در محیط کشت
📌 جمعبندی حرفهای:
این ماده انتخاب کساییه که بهجای آزمون و خطای پرهزینه، میخوان مستقیم به نتیجه برسن.
🔘 دریافت قیمت و مشاوره تخصصی
🔘 ثبت سفارش فوری
واتساپ: 09129618292
کاربرد محیط کشت XLD آگار
محیط کشت XLD (Xylose Lysine Deoxycholate Agar) یک محیط کشت بیوشیمیایی است که به عنوان یک محیط انتخابی و تخصصی در آزمایشگاههای میکروبیولوژی و بیوشیمی برای تشخیص و شناسایی باکتریهای ایشریشیا کلی (Escherichia coli) و باکتریهای مرتبط با این گونه مورد استفاده قرار میگیرد.
این محیط کشت به علت ویژگیهای خاص خود در تشخیص عفونتهای باکتریایی و تحقیقات میکروبیولوژی مفید است. دستهای از کاربردهای محیط کشت XLD به شرح زیر است:
- شناسایی باکتریهای ایشریشیا کلی (E. coli): محیط کشت XLD از طریق جلب و رشد باکتریهای ایشریشیا کلی بر اساس ویژگیهای مخصوص به این گونه از دیگر باکتریها تمیز میکند. باکتریهای ایشریشیا کلی به عنوان نمونههای معمول در تستهای میکروبیولوژی و تحقیقات مختلف مورد استفاده قرار میگیرند. به عنوان مثال، در تحقیقات مرتبط با آلودگی آب و غذا، ایشریشیا کلی به عنوان نشانگر آلودگی میکروبی مورد استفاده قرار میگیرد.
- تشخیص عفونتهای باکتریایی: محیط کشت XLD میتواند به عنوان یک ابزار تشخیصی در تشخیص عفونتهای باکتریایی در نمونههای کلینیکی مانند ادرار، مدفوع، و ادمها مورد استفاده قرار گیرد. باکتریهای ایشریشیا کلی که در نمونهها حضور داشته باشند، میتوانند با استفاده از این محیط شناسایی شوند. محیط کشت XLD آگار کدمرک 105287
- تحقیقات مختلف در زمینه میکروبیولوژی: محیط کشت XLD در تحقیقات مختلف میکروبیولوژی، به ویژه در زمینههای مرتبط با علم بهرهبرداری و علم انتقال ویروسها و باکتریها، استفاده میشود. این محیط کشت به محققان اجازه میدهد باکتریها را از نمونههای مختلف جدا کرده و شناسایی کنند. محیط کشت XLD آگار کدمرک : 105287
- تحقیقات مرتبط با آلودگی محیط زیست: محیط کشت XLD در تحقیقات مرتبط با آلودگی محیط زیست و تعقیب منابع آلوده به باکتریها مورد استفاده قرار میگیرد. این محیط کشت به شناسایی و جداسازی باکتریها در نمونههای مختلف زیستی کمک میکند. محیط کشت XLD آگار کدمرک : 105287
- تحقیقات در زمینه علم دامپزشکی و ایمنی محصولات غذایی: محیط کشت XLD در تحقیقات مرتبط با علم دامپزشکی و ایمنی محصولات غذایی مورد استفاده قرار میگیرد. باکتریهای مختلف که ممکن است در غذاها و محصولات دامی وجود داشته باشند، با استفاده از این محیط کشت تشخیص داده میشوند.
قیمت و نحوه سفارش
قیمت محیط کشت XLD آگار بر اساس بستهبندی و موجودی روز متغیر است. برای دریافت قیمت دقیق و ثبت سفارش میتوانید از طریق گزینههای زیر اقدام نمایید.
اگر میخواهید محیط کشت XLD آگار را بدون دردسر و با دقت بالا تهیه کنید،
محیط کشت XLD آگار مرک آلمان با کد 105287 دقیقاً همان چیزی است که آزمایشگاهت نیاز دارد.
👉 خرید مطمئن از دانش پژوهان شیمی
👉 مناسب دانشجویان، پژوهشگران و مراکز تحقیقاتی
👉 آماده استفاده، دقیق و قابل اعتماد
کاربردهای محیط کشت XLD آگار
محیط کشت XLD آگار کد 105287 بهطور گسترده در موارد زیر استفاده میشود:
-
جداسازی و شناسایی Salmonella spp.
-
شناسایی Shigella spp.
-
آزمایشگاههای تشخیص طبی
-
کنترل کیفیت صنایع غذایی و نوشیدنی
-
آزمایش آب و فاضلاب
-
تحقیقات میکروبیولوژی دانشگاهی
ساختار محیط کشت XLD آگار
محیط کشت XLD (Xylose Lysine Deoxycholate Agar) یک محیط کشت بیوشیمیایی است که به عنوان یک محیط انتخابی برای تشخیص و شناسایی باکتریهای ایشریشیا کلی (Escherichia coli) و باکتریهای مرتبط با این گونه مورد استفاده قرار میگیرد. این محیط کشت دارای ترکیبی از مواد مختلف است که شرایط مناسبی را برای رشد باکتریها فراهم میکند. در ادامه، ساختار محیط کشت XLD آگار را توضیح میدهیم: محیط کشت XLD آگار کدمرک : 105287
- پپتون (Peptone): پپتون یک ترکیب پروتئینی هیدرولیز شده است که نیتروژن و مواد مغذی دیگر را فراهم میکند. این ماده به عنوان منبع اصلی نیتروژن و مواد مغذی برای رشد باکتریها در محیط کشت عمل میکند.
- گلوکز (Glucose): گلوکز به عنوان منبع کربن و انرژی برای رشد باکتریها استفاده میشود.
- لکتوز (Lactose): لکتوز نیز به عنوان یک منبع اضافی کربن و انرژی برای باکتریها عمل میکند.
- آگار (Agar): آگار یک ماده ژلزنی جامد است که به عنوان ماده ژلزنی در محیط کشت عمل میکند. این ماده باعث ایجاد سطح جامد و پایدار در محیط کشت میشود که باکتریها بر روی آن میرویند. محیط کشت XLD آگار کدمرک 105287
- ترکیبات معدنی: محیط کشت XLD شامل ترکیبات معدنی مانند سولفات سدیم (Sodium Sulfate) و کلرید پتاسیم (Potassium Chloride) است که به عنوان منابع معدنی برای رشد باکتریها حضور دارند.
- عوامل تفکیک کننده (Selective Agents): محیط کشت XLD شامل عوامل تفکیک کننده نیز میشود. این عوامل شامل دئوکسیکولات سدیم (Sodium Deoxycholate) و سولفید فریروز (Ferric Sulfide) میشوند که به عنوان عوامل تفکیک کننده جهت تشخیص و شناسایی باکتریهای ایشریشیا کلی و ایشریشیا تیفی (Escherichia typhi) عمل میکنند.
- مواد اندیکاتور (Indicator Agents): محیط کشت XLD شامل مواد اندیکاتور نیز میشود. این مواد شامل قرقره (Phenol Red) است که به عنوان اندیکاتور pH در محیط عمل میکند و تغییر رنگ محیط کشت در صورت تشکیل گاز هیدروژن سولفید توسط باکتریها را نشان میدهد. محیط کشت XLD آگار کدمرک : 105287
- ترکیب ایزوله کننده: ترکیب ایزوله کننده شامل کزین (Xylose) است که به عنوان منب
ویژگیهای محیط کشت XLD آگار
محیط کشت XLD آگار (Xylose Lysine Deoxycholate Agar) یک محیط کشت انتخابی و افتراقی است که عمدتاً برای جداسازی و شناسایی باکتریهای رودهای، بهویژه جنسهای سالمونلا و شیگلا، مورد استفاده قرار میگیرد. این محیط کشت ویژگیهای خاصی دارد که آن را برای شناسایی این میکروارگانیسمها بسیار کاربردی میکند:
ترکیبات انتخابی:
دزوکسیکولات: بهعنوان یک عامل انتخابی عمل کرده و از رشد باکتریهای گرم مثبت جلوگیری میکند.
لیزین: بهعنوان یک منبع اسیدآمینه برای شناسایی فعالیت دکربوکسیلازی سالمونلا عمل میکند.
ترکیبات افتراقی:
زیلوز: منبع کربوهیدراتی است که سالمونلا تخمیر کرده و اسید تولید میکند، اما شیگلا توانایی تخمیر آن را ندارد.
فریک آمونیوم سیترات و تیوسولفات سدیم: برای تشخیص تولید سولفید هیدروژن توسط برخی باکتریها مانند سالمونلا استفاده میشوند.
شاخصهای رنگی:
فنلرد: بهعنوان شاخص pH عمل میکند و تغییر رنگ محیط به دلیل تخمیر کربوهیدراتها یا تجزیه لیزین را نشان میدهد.
ویژگیهای ظاهری کلنیها:
سالمونلا: کلنیهای قرمز با مرکز سیاه به دلیل تولید سولفید هیدروژن.
شیگلا: کلنیهای قرمز بدون مرکز سیاه.
سایر باکتریهای تخمیرکننده زیلوز: کلنیهای زردرنگ.
pH محیط: محیط کشت XLD دارای pH حدود 7.4 است که شرایط ایدهآلی برای رشد باکتریهای هدف فراهم میکند.
این ویژگیها باعث شده است که محیط کشت XLD یک ابزار قدرتمند در میکروبیولوژی بالینی، بهداشت مواد غذایی و تحقیقات مرتبط با بیماریهای عفونی رودهای باشد.
اگر میخواهی محیط کشت XLD آگار مرک آلمان را بدون دردسر و با دقت بالا تهیه کنی،
محیط کشت XLD آگار مرک آلمان با کد 105287 دقیقاً همان چیزی است که آزمایشگاهت نیاز دارد.
👉 خرید مطمئن از دانش پژوهان شیمی
👉 مناسب دانشجویان، پژوهشگران و مراکز تحقیقاتی
👉 آماده استفاده، دقیق و قابل اعتماد
مزایا و ویژگیهای محصول
-
✔ برند معتبر مرک آلمان
-
✔ نتایج دقیق و تکرارپذیر
-
✔ انتخابی و افتراقی قوی
-
✔ مناسب آنالیزهای استاندارد میکروبی
-
✔ سازگار با پروتکلهای بینالمللی
-
✔ کیفیت تضمینشده توسط دانش پژوهان شیمی
خرید محیط کشت XLD آگار مرک آلمان با کد 105287
شرکت دانش پژوهان شیمی که نمایندگی مرک آلمان و نمایندگی سیگماآلدریچ در ایران، با همکاری کارشناسان مجرب خود در بخش فنی و فروش، جهت تامین مواد اولیه پژوهش های تحقیقاتی ماده های با کیفیت بالا و قیمت مناسب را فراهم نموده است. شما می توانید جهت خرید محیط کشت XLD آگار مرک آلمان با کد 105287 با بخش فروش شرکت دانش پژوهان شیمی تماس حاصل بفرمایید و پس از دریافت پیش فاکتور و اطمینان حاصل نمودن از صحت نام محصول، کد، شماره CAS نامبر مواد شیمیایی درخواستی اقدام به ثبت سفارش نمایید تحویل کالاهای خریداری شده و زمان تحویل آنها به صورت زیر می باشد.
- زمان ارسال سفارشات از انبار: ۲۴ تا ۴۸ ساعت کاری می باشد
- نحوه ارسال کالای مشتریان: تهران توسط پیک
- ارسال شهرستان: توسط شرکت های حمل و نقل ( ترمینال، پست، تیپاکس)
قیمت فروش محیط کشت XLD آگار مرک آلمان با کد 105287
شرکت دانش پژوهان شیمی یکی از بزرگترین وارد کنندگان و فروشندگان مواد شیمیایی، آزمایشگاهی بخصوص فروش محیط کشت XLD آگار مرک آلمان که از محصولات نمایندگی مرک آلمان می باشد. این شرکت در زمینه واردات محصولات از تجربه بسیار بالایی برخوردار است. شما می توانید جهت تهیه این محصولات (اصلی) با بخش فروش شرکت تماس گرفته و با کارشناسان این شرکت در ارتباط باشید. از طریق کانال واتساپ شرکت نام محصول به همراه میزان نیاز خود را ارسال تا در کمترین زمان پاسخ استعلام خود را دریافت نمائید. امیدواریم بتوانیم با ارائه محصولات اصلی و با بهترین کیفیت شما را برای رسیدن به اهدافتان یاری نمائیم.
جهت محصولات بیشتر واستعلام سریع قیمت محیط کشت XLD آگار مرک آلمان میتوانید از طریق کانال واتساپ شرکت با ارسال نام ماده و مقدار نیاز در کمترین زمان پاسخ استعلام خود را دریافت نمائید.
راههای ارتباطی
شماره های تماس:
021-66859216
021-66859220 (ساعات تماس:8.30 الی 19)
واتساپ:09129618292 (24ساعت)
استعلام قیمت مواد شیمیایی آزمایشگاهی و تحقیقاتی
Last Updated on 01/02/2026 by adminm








